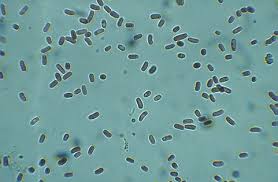

A 2008. Év Bortermelője díj nyertese: Konyári János a Balatonboglári borvidékről, akinek ezúton is gratulál a Borhírek Online szerkesztősége ( már régebben kellett volna...) 1974 Diplomát szerzett a Kertészeti és Élelmiszeripari Egyetemen Külöldi szakmai tapasztalatok (egy – egy szüret erejéig): 1984 Henkel Pezsgőgyár, Németország LOLIENSE 2003 vörös LOLIENSE 2005 vörös Konyári János, Balatonboglári borvidék
A címet a nyertes bortermelő időbeli korlát nélkül jogosult viselni, azonban a megválasztást követő egy év elteltével csak a választás évének feltüntetésével együtt használhatja.
A nyertes szakmai önéletrajzát az alábbiakban olvashatják:
Született: 1951.02.12
Családi állapot: nős
Gyermekek száma: három
1974-1990 Balatonboglári Állami Gazdaságnál előbb műszakvezető, később főborász.
1991 Megalapítja a St. Donatus Pincészetet, melynek 2004-ig főborásza, ügyvezető igazgatója. Ezzel párhuzamosan működik a családi pincészet, mely 2000 óta jelentkezik a piacon.
2003 Elkészül az új borászat, jelenleg 30 ha szőlőn gazdálkodunk.
2004 Megalakul a Rádi Ikon Pincészet 50 ha szőlőterülettel, melynek főborásza, ügyvezető igazgatója.
2007 Az új pincészet 2007-ben készül el.
1988 Yalumba Winery, Ausztrália
1990 Uitkyk Winery, Dél-Afrika
Az utóbbi évek borverseny eredményei:
Concours mondial de Brussel Aranyérem
Pannon Bormustra Csúcsbor
Citadelles du Vin de Bordeaux Trophée Prestige
LOLIENSE 2003 fehér
Pannon Bormustra Csúcsbor
SESSIO 2003
Concours Mondial de Brussel Nagy Aranyérem
Pannon Bormustra Csúcsbor
Citadelles du Vin de Bordeaux Trophée Excellence
Országos Borverseny Aranyérem
LOLIENSE 2006 fehér
Pannon Bormustra Csúcsbor
A díjért versengők voltak, a jelölés során, az öt legtöbb szavazatot kapott borász (ABC sorrendben):
Légli Ottó, Balatonboglári borvidék
dr. Lőrincz György, Egri borvidék
Szöllősi Mihály, Ászár – Neszmélyi borvidék
Vida Péter, Szekszárdi borvidék
bor, pince, borászat, szőlő, pálinka, párlat, hírek .. e-mail: tester@fw.hu
2008.12.05. 20:49
Konyári János az év borásza
Címkék: balaton bor borász konyári jános év borásza
Szólj hozzá!
2008.12.05. 20:00
Mazsolázzon a magyar boros érmek között
Címkék: bor borverseny borérem
Áttekíntés a 2008-ban zajlott jelentősebb nemzetközi borversenyeken elért magyar eredményekről.
 14. Vinalies Internationales 2008
14. Vinalies Internationales 2008
- verseny helyszíne: Párizs, Franciaország
- verseny időpontja: 2008. február 29 - március 4.
- eredményt elért borok teljes listája: itt
Magyar eredmények
 Monde Selection 2008
Monde Selection 2008
- verseny helyszíne: Bruxelles, Belgium
- verseny időpontja: 2008. március
- eredmények országonként: itt
Magyar eredmények
 16° Concorso Enologico Internazionale - Vinitaly 2008
16° Concorso Enologico Internazionale - Vinitaly 2008
- verseny helyszíne: Verona, Olaszország
- verseny időpontja: 2008. március 26 - 30.
- eredményt elért borok listája: itt
Magyar eredmények
 32. Challenge International du vin 2008
32. Challenge International du vin 2008
- verseny helyszíne: Blaye-Bordeaux, Franciaország
- verseny időpontja: 2008. április 12.
- eredményt elért borok országonként: itt
Magyar eredmények
 5. Le Mondial du Rosé 2008
5. Le Mondial du Rosé 2008
- verseny helyszíne: Cannes, Franciaország
- verseny időpontja: 2008. április 27-29.
- eredmények országonként: itt
Magyar eredmények
 The International Wine and Spirits Competition 2008 (IWSC)
The International Wine and Spirits Competition 2008 (IWSC)
- verseny helyszíne: Surrey, Nagy Britannia
- verseny időpontja: 2008. március - szeptember
- eredményt elért borok listája: itt
Magyar eredmények
 International Wine Challenge 2008 (IWC)
International Wine Challenge 2008 (IWC)
- verseny helyszíne: West Sussex, Nagy Britannia
- verseny időpontja: 2008. május
- eredményt elért borok listája: itt
Magyar eredmények
 Decanter World Wine Awards 2008
Decanter World Wine Awards 2008
- verseny helyszíne: London, Nagy Britannia
- verseny időpontja: 2008 április 21-26.
- eredményt elért borok listája: itt
Magyar eredmények
 15. Sélections Mondiales des Vins Canada 2008
15. Sélections Mondiales des Vins Canada 2008
- verseny helyszíne: Québec City, Kanada
- verseny időpontja: 2008. május 30 - június 5.
- eredményt elért borok listája: itt
Magyar eredmények
 8. Les Citadelles Du Vin 2008
8. Les Citadelles Du Vin 2008
- verseny helyszíne: Bourg-sur-Gironde, Franciaország
- verseny időpontja: 2008. május 17-19.
- eredményt elért borok listája: itt
Magyar eredmények
forrásom a http://www.aborfesztival.hu/index.php?page=eredmenyek&id=46&a=0 54. Moje Vino (Vino Ljubjana) 2008
54. Moje Vino (Vino Ljubjana) 2008
- verseny helyszíne: Ljubljana, Szlovénia
- verseny időpontja: 2008. május 30 - június 2.
- eredményt elért borok listája: itt
Magyar eredmények ![]() 7. Mundus Vini 2008
7. Mundus Vini 2008
- verseny helyszíne: Neustadt, Németország
- verseny időpontja: 2008. augusztus 29 - szeptember 7.
- eredményt elért borok listája: itt
Magyar eredmények  10. Mondial du Pinot noir 2008
10. Mondial du Pinot noir 2008
- verseny helyszíne: Sierre, Svájc
- verseny időpontja: 2008. auguszus 22-24.
- eredményt elért borok listája: itt
Magyar eredmények
Szólj hozzá!
2008.12.05. 09:32
Verseny + vadhús + pálinka
Címkék: verseny pálinka vadhús

Vadhús és pálinka: csak legálisan A borsodi, hevesi és nógrádi vadászkamarák, a gyöngyösi főiskola, természetvédők és a házigazda mátrafüredi középiskola rendezi meg immár negyedik alkalommal jövő februárban az Észak-Magyarországi Régió erdészeinek és vadászainak bor- és pálinkaversenyét, amihez a másodig vadételfőző verseny is kapcsolódik majd. Dr. Wachtler István, a társszervező Károly Róbert Főiskola Agrár-, és Vidékfejlesztési Tanszékének dékánja szerint ez a verseny is mutatja az észak-magyarországi régió működőképességét. Úgy vélte: a mezőgazdaság ma már többfunkcióssá vált, hiszen az alapvető termelő folyamatok mellé sikerrel társulnak a kiegészítő tevékenységek is. Azaz jut idő és energia a mellékjövedelmet termelő, szórakoztató "hobbira" is. Hozzátette: nem elhanyagolható a valódi szakemberek bemutatása, akár példaképként állítása sem a következő erdész-vadász generáció számára. - Tavaly már száz mintánál többet jelöltek a versenyre - tudatta a Mátra Szakképző Iskola igazgatóhelyettese, Fülöp Pál. - Azóta viszont életbe lépett az új pálinkatörvény, ami korlátok közé szorítja az idei versenyt. Most már csak szőlőből, valódi gyümölcsből, törkölyből, borból, avagy seprőből készülhetnek az italok, s el kell felejteni a mesterséges adalékokat, színezőanyagokat, sőt: a hozzáadott cukrot is. Az idegen anyagok ugyanis egyszerű szeszesitallá minősítik le az efféle innivalókat. Az egyik cél, hogy a pálinkák megfeleljenek a nemzetközi versenyek bírálati szempontjainak, ám a zsűri kíváncsi lesz arra is, mely borok, pálinkák illenek legjobban a szarvasból, fácánból, vagy vaddisznóból készülő ételek mellé - innen az "árukapcsolás". Borból vöröset, fehéret és rozét minősítenek, pálinkából valódi gyümölcsből érlelteket és szőlő-, illetve törkölypárlatokat várnak. Feltétel, hogy a benevezett borokból legalább 100 liternek, pálinkából pedig minimum 10 liternek kell "készleten lennie". Ez utóbbihoz kötelező a származási igazolás is. A mintákat 2009. január 26-tól február 3-ig veszik át a Mátra Szakképző Iskola portáján, a verseny február 5-én, az ünnepélyes eredményhirdetés - melyhez csatlakozik a vadételfőző verseny döntője is - február 13-án lesz. A rendezvénysorozat éke, a díjak kiosztása február 28-án következik, a XI. Erdész-Gazdász-Vadászbálon, szintén Füreden. A kategóriagyőztesek - mindaddig, míg futja a győztes "munícióból" - használhatják a rendezvény emblémáját védjegyként. Dr. Vasas Joachim, a Mátra Szakképző Iskola igazgatója kifejtette: nincs más alternatíva, csak a minőség, mind a pálinkák, borok felhozatalában, mind a szervezésben. forrásom a http://www.heol.hu/cikk/195117
Szólj hozzá!
2008.12.05. 09:27
Pál (inka) interjú :-)
Címkék: marketing pálinka törvény

Interjú - Pál József
– Az elsődleges cél, hogy újrapozícionáljuk a minőségi magyar pálinkát, hogy elfogadtassuk az emberekkel ezt a nedűt mint nemzeti italt, illetve hogy az esetlegesen hozzá kapcsolódó negatív asszociációkat eloszlassuk. Sze ret nénk, ha előbb-utóbb az emberek fejében a pálinka elegáns, minőségi italként élne. A november 3-án elfogadott pálinkatörvény egyébként pontosan sza bályozza, mely italt nevezhetünk pálinkának.
Mit mond a törvény, mely italt nevezhetjük annak?
– Csak az nevezhető pálinkának, amely ital Ma gyarországon termett és cefrézett gyümölcsből készült. Emellett szintén fontos, hogy a lepárlást és a palackozást is hazánk ban kellett végezni. Ami még kitétel, hogy a pálinka a gyümölcs mellett nem tartalmazhat semmilyen más hozzáadott anyagot, így például cukrot, szí nezéket vagy mézet sem. A gyü mölcságyon való érlelés azonban megengedett.
Milyen fajtájú gyümölcsből készülhet a pálinka?
– Igazából szinte bármilyen jellegzetes ízű, Ma gyar országon termett gyümölcsből lehet pálinkát készíteni. A legnépsze rűbb pálinkák közé tartozik a szilva és a barack, de készülhet áfonyából, eperből, málnából, meggyből és bodzából is. Mind egyik nek megvan a maga saját, karakteres íze.
Szólj hozzá!
2008.12.05. 09:21
...3 millió hektoliter bor fogy...
Címkék: statisztika bor
Hazánkban éves szinten mintegy 3 millió hektoliter bor fogy.
Magyarországon magyar bort isznak
Ennek a mennyiségnek nagyjából kétharmada folyó borként, egyharmada palackos-üveges kiszerelésben kerül a fogyasztókhoz különféle csatornákon keresztül - derül ki a GfK Hungária Piackutató Intézet a Nemzeti Bormarketing Program keretén belül készített feltáró tanulmányából.
A bor kiválasztása során nagyon gyakran az ár és a könnyű beszerezhetőség játssza a meghatározó szerepet, így egyre többen vásárolnak főleg importborokat a hipermarketekben, de a borvásárlás szempontjából előtérbe kerültek a diszkontok is, ahol ma még elsősorban hazai borok kaphatók. Az ízlést természetesen nehéz megváltoztatni, a borfogyasztók többsége pedig nehezen vállalkozik új ízek megismerésére, ehelyett a jól bevált márkákat választja a jól ismert borvidékekről (Eger, Tokaj, Villány). Ez különösen igaz akkor, ha ajándékot keres a vásárló.
A bor kedveltsége a 20 és 60 év közötti korosztályban egyenletesnek mondható. Kiemelkedő a bor nemzeti ital jellege. A növekvő hazai identitástudatot mutatja, hogy az imázs szempontjából a fogyasztóknak nagyon fontos, hogy a bor magyar eredetű legyen - azaz ha hasonló áron találnak hazai illetve importból származó bort, akkor jellemzően a magyar eredetűeket részesítik előnyben.
forrásom a http://www.napi.hu/default.asp?cCenter=article.asp&placein=hirkereso&nID=390080
Szólj hozzá! · 1 trackback
2008.12.05. 09:07
Rubaiyat – a Szalay-Szőke-Tóth Trió koncertje
Címkék: zene vylyan bor művészet borvers
Rubaiyat – Omar Khajjam megzenésített verseit adja elő a Szalay-Szőke-Tóth Trió Helyszín: Pécsi Kulturális Központ, Dominikánus Ház, Színház tér 2. egy pohár borra mindenki a vendégünk! Közreműködik: Szőke Szabolcs - gadulka, sarangi, kalimbák borról szóljanak mind a gyászdalok, BŐVEBBEN: Szalai Péter A Budapesten született Szalai Péter 16 évesen kezdett hivatásszerűen foglalkozni az indiai klasszikus zenével. Kurtág György ösztönzésére a legnépszerűbb ütőhangszert, a tablát választva hangszeréül. Kezdetben a Delhi gharana (iskola) két kiemelkedő képviselőjétől, Anthony Dasstól és Ustad Munnu Khantól tanult, majd a ’80-as évek második felében a világhírű tabla-mester Ustad Alla Rakha fogadta tanítványává. Napjainkban szigorúan követi a Punjab gharana hagyományait. 1987 óta különleges mester-tanítvány kapcsolatban áll Pandit Ravi Shankarral, akit nem csak az indiai klasszikus zene területén tekint gurujának (mesterének). Rendszeres vendége az indiai zenei fesztiváloknak muzsikusként is, de intenzív kapcsolata mesterének fiaival - Ustad Zakir Hussain, Fazal Quereshi és Toufiq Quereshi – sem szakadt meg Ustad Alla Rakha 2000-ben bekövetkezett halála óta. Amellett, hogy a Calcutta Trió tagjaként 1980 óta több ezer koncertet adott, kiemelkedő kvalitású indiai zenészek választották partnerükévé Európában a ’90-es évektől kezdődően: Pr. Debu Choudury, Nandkishor Muley, Gaurav Mazumdar, Shubhendra Raoj. Tóth Evelin A fiatal, különleges hangú énekesnő, először a Hólyagcirkusz Társulat zenés darabjaiban dolgozott együtt Szőke Szabolccsal. Ebből az együttmködésből született az ötlet, hogy egy alapvetően énekhangra épülő, vonóskíséretes triót alakítsanak. Énekstílusára a klasszikus éneklés és a keleti tradicionális énektechnikák egyaránt jellemzőek. 2006-ban elnyerte a legjobb énekesnnek járó díjat a szegedi Thealter Fesztiválon. Szőke Szabolcs Budapesten élő és tevékenykedő zenész, képzőművész és színházi alkotóművész. Zenei tanulmányait klasszikus hegedűn kezdte és csak később fordult érdeklődése a különleges hangzású, főként keleti vonós hangszerek (gadulka, sarangi, gusla) felé. Ezzel egyidejűleg ritkán hallott és kevésbé ismert hangszereket tervezett, többet meg is valósított különböző színházi produkciókban és koncerteken. Tradicionális, de mára már elfeledett, szinte egyáltalán nem használt hangszereket (hólyaghegedű) újra felfedezett és produkcióiban fontos dramaturgiai szerephez juttatta azokat. Mindemellett képzőművészként is tevékenykedett, egyéni és csoportos kiállításokon, és ezáltal a látványtervezés a színházon belül igen közel állt hozzá. Zenészként először a színház keretein belül kezdett el dolgozni 1971-81 között állandó munkatársa és egyik alapítója volt a nemzetközileg is jegyzett Stúdió "K" Színháznak. És nem utolsó sorban magáról a költőről: Omar Khajjám A perzsa csillagász-költő egyike a világirodalom legmodernebb alkotóművészeinek. Egyszerű mint egy szél- és vízformálta sokezeréves szikladarab, de éppen annyira bonyolult is. Pályájának nagy részét a szeldzsuk birodalom fénykorában töltötte el, amelyet a katonai hódítás - a határok kiterjesztése az Égei-tengertől az Indusig - épp úgy jellemzett, mint a jólét és a gazdagság növekedése, a tudomány fellendülése. Ám megélte ennek a birodalomnak a bukását, sőt anarchiába züllését, szétesését is. Életének és tevékenységének nagy részét homály borítja, de műveinek keletkezését és utóéletét is. Költeményeit sosem rendezte kötetbe, többnyire szűk baráti körben mondta el vagy olvasta fel őket, s így csak szájhagyomány útján terjedhettek. Tanítványai és tisztelői csak később állítottak össze belőlük gyűjteményeket, s ezek a gyűjtemények, minthogy utólagosak és nem teljesen megbízható forrásokon alapulnak - filológiailag pontatlanok, sokszor bizonyíthatatlan, hogy egyes darabjaik kitől származnak. forrásom a http://www.vylyan.hu/hirek/151
Rubaiyat – a Szalay-Szőke-Tóth Trió koncertje
Időpont: december 14. vasárnap, 19 órakor
Belépő: 800 Ft
Az est támogatója a Vylyan Szőlőbirtok és Pincészet,
Tóth Evelin - ének
Szalai Péter - tabla, ütőhangszerek, kalimbák
borosan leljen a feltámadás,
porom kocsmában leljék angyalok."
Omar Khajjam (fordította: Weöres Sándor)
Keresett muzsikus különböző jazz formációkban: Familiy of Percussion, Wolfgang Dauner és Albert Mangelsdorf vagy Palle Mikkelborg. Etno- illetve fúziós zenei produkciókban is szívesen vesz részt: Makám, Tin Tin Quintet, Mitsoura. Tevékenysége fontos részének tekinti a tanítást a RIMPA (Ravi Shankar Institute for Music and Performing Arts) keretében.

Szőke Szabolcs zenei pályafutása szólistaként a Franciaországban különösen népszerű KOLINDA együttessel kezdődött 1978-79-ben. Ezzel a zenekarral sikerrel szerepelt számos fesztiválon és játszott többek között a párizsi Olympia színpadán, valamint a Théátre de la Ville-ben. Ezen kívül Svájcban, Németországban és Belgiumban is. Majd 1981-ben megalakította a MAKÁM együttest Krulik Zoltánnal, amely a magyarországi kortárs zenét és a különböző népzenéket egységbe olvasztó, szintézisre törekvő zenei formációk közül talán az egyik legismertebb Kelet-Európában. Később 1994-ben néhány ismert jazz muzsikussal együtt megalakítja a TIN-TIN Quartettet (2003-tól Quintett), amely rögtön megalakulásakor óriási sikert aratott a budapesti World Music Festivalon. 2002-től létrehozta az EKTAR együttest.
perzsa költő, matematikus, filozófus, csillagász
1048. május 18. — 1131. december 4.
Szólj hozzá!
2008.12.03. 20:47
Nem borbírálat
Címkék: bor oportó borbírálat wunderlich pince
Közelmúltban Földim megemlítette, mit szólok a Wunderlich pincészet 2008-as oprtójához. Megtisztelt az a bizalom, hogy a magyaros szakácsművészet egyik felkentjének – akárcsak a zrika okán is – én alkossak véleményt egy borról. Persze, lehetne természetes is, miszerint a borbarát Voporto, borbírálat tárgyává teszi az oportót. Úgy gondoltam, azért, jobb ha mégsem. Ki-ki maradjon a szakmájánál, favágó a favágásnál, politikus a hazudozásnál, borszakértő a kóstolásnál, mérnök a mérnöki munkájánál.
Aztán mégis másként alakult. Tegnap, kedvenc kereskedőm „Borműhelye” előtt vezetett el utam, és csak úgy betértem – volna. Volna, mert a mester éppen zárt. Belém bújt a kis ördög. Mondom néki, sebaj, csak egy palack kellett volna, az meg biztos úgy sincs, amit szeretnék. A kulcs megállt a zárban, majd visszafordult. Sebzett vad csak ennyit szólt, az nem létezik, hogy nincs. Melyikre bizsergett rá ennyire a nyelvem, kérdé? Alighogy kiejtettem Földim által megnevezett bort, abból egy fényes palack landolt a kezemben, ajándék dugóhúzóval együtt. Mennyi a mennyi, rebegtem. Majd legközelebb rendezzük, s akkor elmondom milyen volt. Tudni szeretné a véleményemet róla, ő még nem kóstolta. Neki különben sem szakember, hanem felhasználói vélemény kell. Kettő null, oda. Elbúcsúztunk egymástól, s én otthon a megfelelő pince hőmérsékletre hűtöttem a bort. És aztán jött a kóstolás.
 Tisztában vagyok vele, a szakemberek manapság először az illat, majd az íz, végül pedig a szín alapján értékelik a borokat. Tegyék. Szerintem, minden pillanatnak, minden helyzetnek, s minden embernek megvan a jó, sőt kiváló bora. Én speciel a kevésbé testes, enyhén savas, (szőlő)gyümölcsös, kiegyensúlyozott, tiszta zamatú, selymes, száraz, nem túl tolakodó illatú, döntően fehér nedűket kedvelem. A vörös borok kóstolgatását, orvosi javallatra, egyébként pedig korlátoznom (Lásd: Köszvény, harcsa, unikum című írás). Így egyértelműen látható, hogy számomra mely szőlőszármazékok a kedvesek. Amikor bort iszom, az összhatás érdekel, valójában az az érzés, ami a megfontolt fogyasztás után marad. Ha kellemes, akkor az ital megfelelő számomra, ha nem, mehet a süllyesztőbe. Legyen az bármilyen sztárolt hazai, esetleg külföldi pincészet, vagy egy megdicsőített palack. Jómagam, ekként minősítem az utamba kerülő borokat.
Tisztában vagyok vele, a szakemberek manapság először az illat, majd az íz, végül pedig a szín alapján értékelik a borokat. Tegyék. Szerintem, minden pillanatnak, minden helyzetnek, s minden embernek megvan a jó, sőt kiváló bora. Én speciel a kevésbé testes, enyhén savas, (szőlő)gyümölcsös, kiegyensúlyozott, tiszta zamatú, selymes, száraz, nem túl tolakodó illatú, döntően fehér nedűket kedvelem. A vörös borok kóstolgatását, orvosi javallatra, egyébként pedig korlátoznom (Lásd: Köszvény, harcsa, unikum című írás). Így egyértelműen látható, hogy számomra mely szőlőszármazékok a kedvesek. Amikor bort iszom, az összhatás érdekel, valójában az az érzés, ami a megfontolt fogyasztás után marad. Ha kellemes, akkor az ital megfelelő számomra, ha nem, mehet a süllyesztőbe. Legyen az bármilyen sztárolt hazai, esetleg külföldi pincészet, vagy egy megdicsőített palack. Jómagam, ekként minősítem az utamba kerülő borokat.
Hamvas Béla, A bor filozófiája boncolgatása során, természetesen egy másfajta kategorizálást ír le. „Megkülönböztetek szőke hajú (világos) és sötéthajú (vörös) borokat; aztán hím (száraz) és női (édeskés) borokat; sőt megkülönböztetek szoprán, alt, tenor, basszus hangú, egyszólamú és többszólamú, szimfonikus borokat. De meg szoktam különböztetni szoláris (napszerű), lunáris (holdszerű) és asztrális (csillagszerű) borokat is. A borra egyébként mindennemű megkülönböztetés egészen könnyen alkalmazható. Van például logikus és misztikus bor, vizuális és akusztikus, jobbról balra és balról jobbra folyó bor, és így tovább a végtelenségig. Minden bor az embert újabb és újabb megkülönböztetési feladatok elé állítja.” S, ez milyen igaz.

Akkor hát, tegyük a dolgunkat mi is. Wunderlich villányi pincészet, Portugieser 2008 Márton-napi újbor. Tudom, nem ez lenne a legfontosabb, de engem nagyon ingerel. Én most, speciel, akkor is egy Villányi Oportót kóstolgatok. Üde, könnyű, gyümölcsös, selymes, klasszikus száraz vörösbor. Illata harmonizál az ízével. Színe alapján testesebb ital is elképzelhető lenne, de mozgása azért, árulkodik. Fiatalsága, a csersav hiánya miatt domináló – általam kedvelt – savassága okán a nehéz, zsíros húsos ételek, de még sült, halak mellé is fogyasztható. Tapasztalatom szerint, a palack tartalmának huzamos vizsgálata kapcsán különös figyelmet érdemes fordítani a bor viszonylag alacsony hőmérsékletének megtartására, s ezzel a kellemes összhatás még az utolsó kortyoknál is bizosítható., ha józanok vagyunk. Félretéve a már említett fehérboros elkötelezettségemet, mindenkinek jó szívvel ajánlom. Földimnek, különösen.
forrásom a http://szkajparasztok.blog.hu/2008/11/25/nem_borbiralat
Szólj hozzá!
2008.12.03. 20:40
I. Szt. Miklós Pálinka Ünnep a Városligetben
Címkék: pálinka pálinkafesztivál hellókarácsony

I. Szt. Miklós Pálinka Ünnep a Városligetben
Hagyományteremtő szándékkal a Szt. Miklós Pálinka Ünnepen helyezik be a Magyar Mezőgazdasági Múzeumba, mint megőrzendő nemzeti kincset Magyarország Legjobb Pálinkáját!
Először rendezik meg a Vajdahunyadvár területén ezt az ünnepet, december 6-hoz kötődően, hiszen Szent Miklós Napja egyben a Magyar Pálinka Napja, mert Ő a pálinkások védőszentje is. Hagyományteremtő szándékkal a Szt. Miklós Pálinka Ünnepen helyezik be a Magyar Mezőgazdasági Múzeumba, mint megőrzendő nemzeti kincset a Magyar Országos Pálinka, Nemzetközi Gyümölcspárlat Verseny eredménye alapján Magyarország Legjobb Pálinkáját! Idén egyszerre 3 pálinka vonul be a történelembe, hiszen 2006 óta adják ki ezt a címet.
A Magyar Országos Pálinka Nemzetközi Gyümölcspárlat Versenyt 2000 óta szervezik meg Gyulán a Kisüsti Pálinka Fesztivál Keretében. A 2009-es versenykiírásban már Budapest is szerepel, hiszen az áprilisi, gyulai eredményhirdetés győztes pálinkáját ezt követően minden év decemberében elhelyezik majd a Magyar Mezőgazdasági Múzeumban. 2002-től adják ki az Ország Legjobb Kereskedelmi Pálinkája címet, valamint az Ország Legjobb Bérfőzetett Pálinkája címet, valamennyi szakmai szervezet támogatásával.
2002-től adják ki az Ország Legjobb Kereskedelmi Pálinkája címet, valamint az Ország Legjobb Bérfőzetett Pálinkája címet, valamennyi szakmai szervezet támogatásával.
Program:
A fesztiválsátorban folyamatos programok, minden nap délelőtt 10.00 órától pálinkások, kolbászosok ínycsiklandó gasztronómiai kiállítása és vására, népművészek termékeivel színesítve.
Koncertek:
December 4. csütörtök 20.00 Republic koncert
December 5. péntek 20.00 Apostol koncert
December 6. szombat 18.00 Mega Fásy Mulató
December 7. vasárnap 18.30 Anti Fitness Club koncert, 20.30 Bikini koncert
Nyitva tartás: minden nap 10 órától
Jegyárak: a rendezvényre való belépés 17.30 óráig ingyenes, 17.30 után a belépő 1.300 Ft (10 éves kor alatt ingyenes).
Bővebb információ: www.palinkafesztival.hu »
Szólj hozzá!
2008.12.03. 20:32
A Kossuth téren ünneplik a pálinkát
Címkék: budapest pálinka miklós pálinka lovagrend

A Kossuth téren ünneplik a pálinkát
A Magyar Pálinka Lovagrend immár harmadik éve december 6-át tartja az év egyik legfontosabb napjának. Mikulás napja ugyanis ma már a pálinka saját ünnepnapja is. December 5. és 7. között rendezik a Pálinka Árkádiát a Kossuth téren, a Földművelésügyi és Vidékfejlesztési Minisztérium épületének árkádjai alatt.
zent Miklós a pálinkafőzők védőszentje 2006 decembere óta. Tavaly a hegyeshalmi határátkelőnél az országba belépők egy-egy kis üveg pálinkát kaptak ajándékba, Budapesten pedig a pálinka ügyéért legtöbbet tett szakmabelieknek átadták a Magyar Pálinkáért Érdemrendet. Ezt idén is kiosztják.
December 5-én délután két órakor az FVM árkádja alatt újra nyit a Pálinka Árkádia, amelynek fővédnöke Gráf József miniszter. Fábián László és Balogh Gábor öttusa olimpikonok is vállalták, hogy népszerűsítik ezt a hungarikumot.
Ezúttal az eredetvédett pálinkák, köztük a szabolcsi alma, a szatmári szilva, a gönci barack, a békési szilva, a kecskeméti barack, az újfehértói meggy és a göcseji körtepálinka, valamint az ágyas pálinkák ünnepe lesz elsősorban december első hétvégéje.
Az első napon a lovagrend tagjai a pártoló hölgytagok kíséretében göcseji körtepálinkát kínálnak a Nagy Imre téren, a metró kijáratánál és a Néprajzi Múzeum előtt. Eközben egy látványfőzdében eredeti magyar gyümölcspálinkát főznek, amelyet a vendégek meg is kóstolhatnak. Kaphatók lesznek majd üdítőitalok és pálinkakorcsolyák is.
A budapesti eseményhez vidéki rendezvények is kapcsolódnak. Szombaton Győrben, a Szent Miklós templomban ikonszentelésre és hálaadó istentisztelet lesz, majd felavatják a Magyar Pálinkalovagrend új tagjait. Pannonhalmán bemutatják a Pannonhalmi Pálinkáriumot és a helyi pálinkafőzőt, valamint megáldják Szent Miklós domborművét.  forrásom a STOP >>>http://www.stop.hu/articles/article.php?id=419927
forrásom a STOP >>>http://www.stop.hu/articles/article.php?id=419927
Szólj hozzá!
2008.12.03. 20:17
X. Országos rozé borverseny
Címkék: rozé bor borverseny miklós hellókarácsony
X. Országos rozé borverseny
Kunszentmiklóson, 2008. december 6.-án, hagyományosan Miklós napján kerül megrendezésre az országos rozé borverseny.
Meghívó letöltése itt
A verseny célja a rozé és siller borok, pezsgők minőségének megmérettetése mellett ezen kiváló borok propagálása, fogyasztókkal minél szélesebb körben történő megismertetése, piacra jutásuk elősegítése. Sajtón keresztül a fogyasztók tájékoztatása a sajátos készítési technológiáról, hogy ennek köszönhetően a rozé és siller borok egyedülálló módon egyesítik a kékszőlőből származó zamatgazdagságot, a fehérborok frissességével, üdeségével.
A bíráló bizottság tagjai a helyszínnek és időpontnak megfelelően kizárólag Miklósok: Dr. Kállay Miklós professzor úr, a Budapesti Corvinus Egyetem Borászati Tanszék vezetőjének elnökletével történt.
Szentmiklós települések
| Dánszentmiklós | Pusztavacstól észak fel kb 10. km |
| Dunaszentmiklós | Tata fölött közel az országhatárhoz a Dunához |
| Fertőszentmiklós | Kapuvár és Sopron között, közel a fertő tóhoz |
| Kisszentmiklós | Dumaföldvártól északra kb 6 km. |
| Kunszentmiklós | Kiskunhalas Budapest vonalon |
| Mernyeszentmiklós | Somogyban, Kaposvár és a Balaton kb. félúton |
| Magyarszentmiklós | Nagykanizsától kb. 15km Zalaegerszeg felé úton |
| Mosonszentmiklós | Győr és Mosonmagyaróvár között kb. félúton |
| Rábaszentmiklós | Győrtől délnyugatra Pápa felé |
| Sárszentmiklós | Székesfehérvártól Délre Sárbogárd melle |
| Szigetszentmiklós | Csepel szigeten Pest alatt |
| Őrszentmiklós | Galgamácshoz közel |
| Tápszentmiklós | Kisbér Pannonhalma közötti úton a Bakony Északi lábánál |
| Tarnaszentmiklós | Abádszalók, Kisköréhez közel |
| Tornyiszentmiklós | Lenti és Letenye közötti félúton a határ mellet |
| Törökszentmiklós | Cegléd – Törökszentmiklós - Hajdúszoboszló - Debrecen |
forrásom a http://www.rozebor.hu/
Szólj hozzá!
2008.11.29. 21:26
A szájüregi baktériumok fokozzák az ízérzést
Címkék: bor borkóstolás
A szájüregi baktériumok fokozzák az ízérzést
Élelmiszervegyészek kimutatták, hogy bizonyos borok, gyümölcsök és zöldségek - a szánkban élő baktériumoknak köszönhetően - egy késleltetett, de intenzív ízérzést okoznak. A modern borkészítés atyjaként ismert néhai Emile Peynaud észrevette, hogy a sauvignon blanc szőlőnek csak enyhe íze van, ha valaki beleherap, de 20-30 másodperccel később hirtelen „egy erőteljes ízélményt tapasztalunk, ahogy a sauvignon íze visszatér." Ahhoz, hogy érezzünk egy illatot, valamilyen illó anyagnak kapcsolatba kell kerülnie az orrüreget bélelő szaglóhámmal. Más kutatók már korábban kimutatták, hogy az utóízt okozó ételek szagtalan kéntartalmú összetevőket tartalmaznak, amelyeket cisztein-S-összeköttetéseknek neveznek, az illó kénkomponens pedig -ami az ételek illatát adja - a tiol nevű előanyagból szabadul fel. Hogy jobban megértsük, hogy a szagtalan előanyagok hogyan válnak szagos származékaikká, dr. Christian Starkenmann és kutatócsoportja 30 mintát vizsgált, amelyek a kéntartalmú tiolt vagy a megfelelő cisztein-S-összeköttetést tartalmazták. A vizsgálatban résztvevő személyek 5 másodperc után kiköpték a mintákat és ezután beszámoltak az ízélményről. Míg a vizsgálat alanyai a tiolok illatát azonnal érezték, 20-30 másodpercig tartott, hogy megérezzék a cisztein-S-összeköttetések illatát. Míg a tiolok illata csupán pár másodpercig volt érezhető, az előanyagok illatát több, mint 3 percig érzékelték. Hogy kiderítsék, a nyál mely összetevői a felelősek a tiolok felszabadulásáért, a kutatók az előanyagokat steril és normál baktériumflórát tartalmazó nyállal vegyítették laboratóriumi körülmények között. A normál nyállal vegyített előanyagok 80%-a lebomlott 24 órán belül, míg a steril nyál esetében a lebomlás sokkal lassabb volt: 4 nap után is csak kevesebb, mint 15%-uk bomlott le. Dr. Starkenmann és munkatársai szerint ez arra utal, hogy a szájüregi baktériumok a felelősek a tiolok felszabadulásáért az utóízzel rendelkező ételek és italok esetében. Az eredmények hasznosak lehetnek olyan ételek kifejlesztésében, amelyek összetett, hosszan tartó ízérzést okoznak. Dr. Starkemann megjegyezte, hogy hasonló mechanizmusok lehetnek felelősek a rossz lehelet és a kellemetlen hónaljszag kialakulásáért is. forrásom a http://bekescsaba.hir6.hu/cikk/24330/081129_a_szajuregi_bakteriumok_fokozzak_az_izerzest
Szólj hozzá!
2008.11.29. 21:14
Workshop
Címkék: bor kecskemét
A Dél-Alföldi Regionális Innovációs Ügynökség Közhasznú Egyesület
„A Mezőgazdaság és az Élelmiszeripar fejlődési irányai a Dél-Alföldi régióban”
címmel workshop-ot szervez 2008. december 03-án szerdán.
Helyszín: Kecskeméti Főiskola Kertészeti Főiskolai Kar 6000 Kecskemét, Erdei Ferenc Tér 1-3.
A rendezvényen való részvétel ingyenes, de előzetes regisztrációhoz kötött!
Fölk Renáta projektmenedzser
DA-RIÜ Khe.6720 Szeged, Kígyó u. 4.
Tel: + 36 62 / 549-500 Fax:+ 36 62 / 549-509
Web:www.darinno.hu
Szólj hozzá!
2008.11.28. 19:11
Írd velünk a hegy történetét!
Címkék: villány vylyan bor művészet
Írd velünk a hegy történetét! … és nyerj Vylyan borcsomagot! A Vylyan Pincészet Classicus borcsaládja 2008 őszétől megújult címkékkel jelenik meg, és ez alkalomból a Vylyan nyereményjátékra hívja a lelkes (vagy leendő) borfogyasztókat. A feladat egyszerű: a monda szereplőit felhasználva egy „új monda” megírása. A téma szabad: szólhat a szőlőről, a borról, a pincészetről, … A történetben azonban szerepeljen Harka a szép leány, az Ördög és a Boszorkány, a Kecskét senki se felejtse, a Kakast, s a Macskát is szerepeltesse. Szárnyaljon hát az alkotó fantázia! A történet lehet bús, vagy komikus, (esetleg tragikomikus), verses, vagy regényes. Műfaji, terjedelmi korlát nincsen, korra, nemre való tekintet nélkül bárki nevezhet. Beküldési határidő: január 8. A zsűri tagjai: A legjobb művet értékes classicus borcsomaggal jutalmazzuk, valamint a nyertes (másodmagával) meghívást kap a Vylyan Pincészet január 17-iVince-napi rendezvényére. További információ: Iványi Emese, 72/579-731; 30/458-11-08; vylyan@vylyan.hu






Az alábbi e-mail címre: vylyan@vylyan.hu
Bächer Iván, író, újságíró, publicista • László Ágnes, újságíró • Méhes Károly, költő, író, újságíró • Nagy Bandó András, humorista, író • Nagy Sebestyén, műsorvezető • Pécsi Borozó magazin
Az eredményről mindenkit e-mailben értesítünk.
Szólj hozzá!
2008.11.28. 19:08
Veszélyes a magyar bor?
Címkék: anglia kutatás bor ...medveanyám...
A londoni egyetem kutatói a nehézfém mennyiségét sokallják

A kutatók szerint, aki nap, mint nap fogyaszt a magas nehézfémtartalmú borokból, az veszélyezteti az egészségét. Arról azonban a cikkekben egyetlen szó sincs, pontosan milyen borokat hasonlítottak össze. A Pécsi Tudományegyetem tanára szerint ráadásul mindenben van nehézfém.
„Hogyha megnézzük, a vízben is van nehézfém, de könnyen lehet, hogy a tejben is találunk nehézfémet. Szóval mindenféleképpen az a kérdés, hogy különböző termékekben ez mennyire közelíti meg, vagy haladja meg azt a határt, amit úgymond már egészségkárosítás” – mondta Sümegi Balázs egyetemi tanár.
Günzer Tamás villányi borász szerint szándékosan próbálják lejáratni a magyar borokat.
„Biztos vagyok abban, hogy megint valamilyen szenzációéhes embernek a műve ez, aki magára fel akarta hívni a figyelmet” – mondta Günzer Tamás.
A villányi borász azt mondja, az Országos Borászati Intézet megvizsgálja az összes bort, és ha határérték feletti lenne a nehézfém tartalmuk, nem engednék forgalomba hozni.
„Mondjuk a réz vagy a vas túlzott mennyiségben van jelen a borban, abban a pillanatban megváltozik a stabilitása. Tehát tegyük fel, egy hidegre úgy reagál a bor, hogy bezavarosodik, üledék képződik - ezt az OBI megvizsgálja. Biztos vagyok benne, ha ilyen magas érték lenne, akkor ezek a borok egészen biztosan nem kerülhetnek forgalomba” - mondta Günzer Tamás borász.
Az angol egyetem kutatóit az RTL Híradó próbálta utolérni, sikertelenül.
Szólj hozzá!
2008.11.24. 08:11
V. Magyarországi Újbor és Sajt Fesztivál
Címkék: fesztivál újbor bor sajt

2008. november 29. szombat 10:00-18:00 óráig Magyarország legjobb újborait kóstolhatja meg. A helyszínen váltható belépőjegy 1500 Ft, melyhez egy fesztivállogóval ellátott poharat kap. Magyarországi Borrendek országos találkozója "Első Magyarországi Újbor futam" 2008. év Újborfelismerő Bajnoksága Borturizmus Börze Bor és az Informatika 2008. november 30. vasárnap 10:00-18:00 óráig Magyarország legjobb újborait kóstolhatja meg. A helyszínen váltható belépőjegy 1500 Ft, melyhez egy fesztivállogóval ellátott poharat kap. 2008. év Újborfelismerő Bajnoksága Borturizmus Börze Biblia Éve Újbor és sajt közönségdíjak átadása Ünnepélyes fesztiválzárás forrásom a http://www.ujboressajtfesztival.hu/
A jubiláló borrendek köszöntése:
20 éves a Magyarországi Borrendek Szövetsége
Alisca Borrend - Szekszárd
Gustodes Vinorum Borrend - Villány
Vinum Vulcanum Borrend - Badacsony
10 éves a Magyar Hölgyek Gasztronómiai és Borrendje - Pécs
résztvevőinek fogadása és köszöntése
DUNA BORRÉGIÓ - PANNON BORRÉGIÓ
Újborfelismerő bajnokság a 18 éven felüliek részére
Magyarországi Pincészetek bemutatkozása
A 40 éves Neumann János Számítógép-tudományi Társasággal együttműködés
Újborfelismerő bajnokság a 18 éven felüliek részére
Magyarországi Pincészetek bemutatkozása
Adventi újbor és sajt ökomenikus szentelése